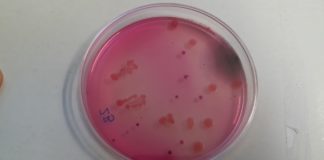
Susret s bakterijama

Radionice Biolog-i-Ja 2023
Radionice za osnovne škole (5. - 8. razred)
Vrijedan kao mrav, dosadan kao muha
Učenici će imati priliku upoznati se sa stručnjacima koji se bave proučavanjem kukaca - entomolozima. Kukci (lat. Insecta) su vrstama najbrojniji razred velike skupine...
Susret s bakterijama
Bakterije su posvuda u našem okolišu. Štoviše, prisutne su i u našem tijelu te na površini naše kože gdje su u većini slučajeva jako...
Razliku učini, za vodu brini!
Voda je neprocjenjiv prirodni resurs koji trebamo čuvati i štedljivo koristiti. Neprestano kruži između Zemlje i atmosfere, a živi organizmi ju uzimaju i otpuštaju...
Pronađi me ako možeš
Životinje su tijekom evolucije razvile brojne prilagodbe koje im omogućavaju bolje preživljavanje, a jedna od njih je i mimikrija. Mimikrija je sposobnost životinja da...
Mikroskop-i-Ja / Zaviri u biljnu stanicu
Zanima vas mikroskop, a do sad niste imali puno prilike mikroskopirati? Volite biljke i zanima vas što se krije u stanicama? Želite promatrati kromosome?...
Na put oko svijeta na Dan planeta Zemlje
22. travnja diljem Svijeta obilježava se Dan planeta Zemlje s ciljem podizanja svijesti o važnosti očuvanja okoliša i poticanja društva da preuzme odgovornost za ...
Male čarolije biologa
Pokus je temelj svakog istraživanja u biologiji, njime se izazivaju, istražuju i rasvjetljavaju biološki procesi te odgovara na svako postavljeno pitanje. Pokus je znanstvena...
Kozmetika s porukom
Kroz radionicu „Kozmetika s porukom“ učenici se mogu upoznati s brzim i jednostavnim načinom izrade prirodne kozmetike, koji mogu primijeniti u svojoj školi i...
Fosili – pogled u Zemljinu prošlost
Fosili su ostaci biljnih i životinjskih organizama iz geološke prošlosti najčešće sačuvani u sedimentima. Oni nam pokazuju kako su izgledali i kako su se...
DJ Enzyme
Gdje se nalaze enzimi? Koja je njihova uloga?
Dok čitate ovaj tekst u vama se odvija na tisuće enzimskih reakcija! Enzimi omogućavaju probavljanje ručka kojeg...
Čarolija mirisa
Biljke sadrže različita eterična ulja koja za njih imaju važnu ulogu. Privlače kukce oprašivače i pridonose razmnožavanju biljaka, daju joj neugodan okus i odbijaju...
Radionice za srednje škole
Šumski detektivi
Cilj radionice “Šumski detektivi” je učenicima dati uvid u metode istraživanja biljnih patogena na primjeru fitopatogene gljive Ophiostoma novo-ulmi, uzročnika holandske bolesti brijesta. Uslijed...
Lov na blago ulicama grada Osijeka
Drugu godinu za redom pozivamo vas da se okušate u Lovu na blago ulicama grada Osijeka. Postanite Lovci na znanstveno blago, uz znanje i želju...